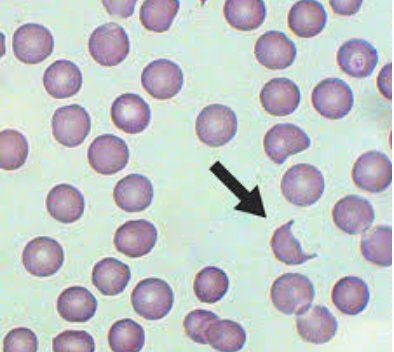

define DIC?
Disseminated intravascular coagulation (DIC) is an acquired syndrome characterised by activation of coagulation pathways, resulting in formation of intravascular thrombi and depletion of platelets and coagulation factors.
outline the causes/risk factors of DIC?
Sepsis/severe infection, major trauma or burns- INFECTION IS PARTICULARLY GRAM NEGATIVE
Some malignancies (acute myelocytic leukemia or metastatic mucin-secreting adenocarcinoma)
Obstetric disorders (amniotic fluid embolism, eclampsia, abruptio placentae, retained dead fetus syndrome)
Severe organ destruction or failure (severe pancreatitis, acute hepatic failure)
Vascular disorders (Kasabach-Merritt syndrome or giant haemangiomas, large aortic aneurysms)
Severe toxic or immunological reactions (blood transfusion reaction or haemolytic reactions, organ transplant rejection, snake bite).
state obstetric complications that can cause DIC?
what vascular disorders can cause DIC?
Kasabach-Merritt syndrome
Giant haemangioma
Large AAA
Describe the pathophysiology of acute DIC?
Endothelial damage and the release of granulocyte/macrophage procoagulant substances (e.g. tissue factor) lead to activation of coagulation
This leads to explosive thrombin generation, which depletes clotting factors and platelets, whilst also activating the fibrinolytic system
This leads to bleeding in the subcutaneous tissues, skin and mucous membranes
Occlusion of blood vessels by fibrin in the microcirculation leads to microangiopathic haemolytic anaemia and ischaemic organ damage
Which maligancies cause DIC?
Acute promyelocytic leukaemia - ACUTE DIC
Lung, breast and GI malignancy - CHRONIC DIC
Describe the pathophysiology of chronic DIC?
IDENTICAL process to acute DI
Happens at a slower rate with time for compensatory responses
The compensatory responses diminish the likelihood of bleeding but give rise to hypercoagulable states and thrombosis can occur
Describe the epidemiology of DIC?
Seen in any severely ill patient
What are the presenting symptoms of DIC?
The patients will tend to be severely unwell with symptoms of the underlying disease
Confusion
Dyspnoea
Evidence of bleeding at atleast 3 unrelated sites= highly suggestive of DIC
what are the signs of DIC on physical examination?
Bleeding features
Haemolytic features
what are the appropriate investigations for DIC and what is seen?
FBC
Peripheral Blood Film
what is seen on the peripheral blood film in DIC?
SHISTOCYTES
what are the signs of chronic DIC?
Signs of deep vein and arterial thrombosis or embolism
Superficial venous thrombosis